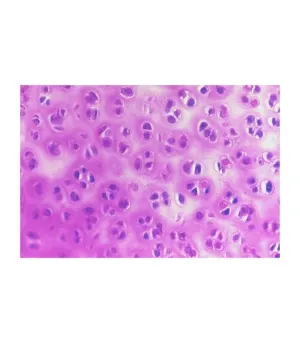

- Materia
- Ciencia infantil a primaria
COLECCIÓN PREPARACIONES BIOLOGÍAGENERAL. 25 PREPA
55,55 €
IGIC incluido
Consultar
55,55 €
IGIC incluido
Consultar
Añadir a favoritos








